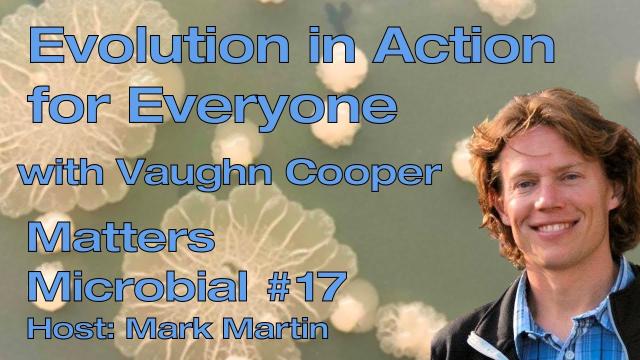

Day 8: Ten Non-Contiguous Days, Ten Films.
This is a lot of fun! So long as I don’t make this too hard or too easy!
Over ten days you pick an image from a film without any title to give away where it is from, so that people can guess. You can also nominate others to do the same. That way more people are in on the game! (or not–your choice 😀 )
But remember: NO SPOILERS! If you recognise a film, don’t say what it is! Say something that indicates you know, but allows others to guess as well. Your messages then become helpful hints!
This is another made for television film.
@Kenny Chaffin Speaking of birds with sticks!
#TenDaysTenFilmsTenFriends or #TenDaysTenFilmsNoFriends
like this
youtu.be/p8tdy_xg-ng?si=ceG3om…
Matters Microbial #17: Evolution in action for everyone with Vaughn Cooper
Today Dr. Vaughn Cooper, Professor in the Department of Microbiology and Molecular Genetics at the University of Pittsburgh, will chat with us about how he a...YouTube
Born in 1917, Egyptian physicist Sameera Moussa studied radioactive isotopes used to create medical images. Her work “laid the groundwork for a revolution in the affordability & safety of nuclear medicine.”
Concerned about the potential use of nuclear weapons during WWII, Moussa organized the Atomic Energy for Peace conference.
She was likely assassinated at age 35 in a case that remains unsolved. arstechnica.com/science/2023/0… #science #history
How physicist Sameera Moussa went from a role model to a mystery
Research success, "Atoms for Peace" activism, and an early death.Ars Technica

This Application Just Dropped Wayland Support?!?
As more and more projects move to Wayland, this one application went the other way and just dropped it's Wayland support by default, that project being the P...YouTube
The Server Side Decoration feature for wayland compositors is still only "unstable", not stable.
tbh I also dont see any point in SSD. We dont need 2 implementations and if you need a "fallback", you only need the fallback and nothing else. Libdecor needs a lot of polishing but thats what should be used, tbh.
Apps need to provide the full experience, because no one else could know what they require to have. As you can see here..
They referred to her as “Moses” for guiding the enslaved from the South to freedom in the North. But, Harriet Tubman’s resistance to slavery extended beyond her role in the Underground Railroad. As a Union Army soldier and spy during the Civil War, she made history by becoming the first woman to lead an armed U.S. military mission.
1/
Image: “Harriet Tubman,” by Mark Fredrickson
Blog: open.substack.com/pub/400years…
Videos:
youtube.com/@400YearsUNLeashed…
Lol @ Threads giving out shitty warnings about suspected automated activity on an account I 100% manually post to.
A warm congratulations to Glenys Oogjes, CEO of #AnimalsAustralia, and recipient of Victoria's Senior Australian of the Year! 🎊🥳
Over her 4 decade stint with Animals Australia, Glenys has made substantial contributions in Australia's animal policy, leading to substantial changes to the welfare of farmed animals throughout Australia.
Her tireless work makes Animals Australia one of the most effective animal advocacy groups, bringing the plight of animals in Australia front and centre to the communities consciousness.
Once again, congratulations Glenys! You are an inspiration to all of us here at Vegan Australia!
animalsaustralia.org/latest-ne…
#AustralianOfTheYear #Vegan #Vegans #Veganism #AnimalRights

Animals Australia CEO named Victoria's Senior Australian of the Year | Animals Australia
Glenys has been a tireless advocate for animals for over four decades.Animals Australia

Margay Leopardus wiedii
Graceful, athletic and beautiful feline of the Amazon jungle, margays are small wild cats endemic to South and Central America. Every margay has a unique spotted pattern on their coat. They depend …Palm Oil Detectives
A Dust Jet from the Surface of Comet 67P
Image Credit: ESA, Rosetta, MPS, OSIRIS; UPD/LAM/IAA/SSO/INTA/UPM/DASP/IDA
apod.nasa.gov/apod/ap231126.ht… #APOD
APOD: 2023 November 26 – A Dust Jet from the Surface of Comet 67P
A different astronomy and space science related image is featured each day, along with a brief explanation.apod.nasa.gov
APOD: 2023 November 26 – A Dust Jet from the Surface of Comet 67P
A different astronomy and space science related image is featured each day, along with a brief explanation.apod.nasa.gov
like this
Just checked all the 13 of 220 folders that were created as belonging to user and group root and that I consider shouldn't exist as owned by root i the folder /smarty3.
In general terms speaking I couldn't find a common property.
They refer to posts or replies by three different users.
Most refer to one specific post.
Two create a page:
Not Found
The requested item doesn't exist or has been deleted.
Request: XYZ
All were created with the theme VIER.
root? It should run as www-data. Same question if you're using the daemon.
So this is a "tricky" one for me as I have no idea what or how to do this.
In the helpers page:
tupambae.org/help/Install#cron…
it only states:
helpers page wrote:
cron job for worker
If you are using a Linux server, run "crontab -e" and add a line like the one shown, substituting for your unique paths and settings:
I did my installation with the help of @hankg's tutorial:
nequalsonelifestyle.com/2022/0…
ubuntu install tutorial wrote:
First log into the server through SSH using your root@<domain> user. Then execute the crontab edit command:
sudo crontab -e
How do I set this so "It should run as www-data."
??
Something like this?
# For more information see the manual pages of crontab(5) and cron(8)
#
# m h dom mon dow command*/5 * * * * cd /var/www/html; su -u friendica /usr/bin/php bin/worker.php
As off now it was running like this:*/5 * * * * cd /var/www/html; /usr/bin/php bin/worker.php
Your suggestion:php command with su -u friendica*/5 * * * * cd /var/www/html; su -u friendica /usr/bin/php bin/worker.php
What we didn't actually clarified is what friendica stands for.
Like to say, is it a "place holder", a variable for a user or application name?
Is "friendica" defined as such in worker.php?
Or would it actually be www-data?
friendica is the name of my local node web server user. You should be writing www-data instead.
Well, this;*/5 * * * * cd /var/www/html; su -u www-data /usr/bin/php bin/worker.php
.. didn't work out.
Looks like cron job didn't execute at all.
The last worker execution was on 2023-12-22 16:25:28 UTC. This is older than one hour. Please check your crontab settings.
Still monitoring this and wondering if some setting and changes while moving the server has to do with this.
Right now there are folder structures like the mentioned created and visible in /smarty3 and /storage.
Of the two folders that have root as owner in the /smarty3 folder, there is one subfolder that exists in the /storage folder and one that doesn't.
The one that does exist in /storage and /smarty3 has the same creation date (Nov 28 2023).
It actually points right now to this very answer above:
/display/0ac89072-1165-95dc-31ec-a8a342054692
That folder contains an completely unrelated unknown avatar.
While trying to nano the file contained in the other folder right now the following message came up:
"File root is being edited by root (with nano 6.2, PID 3334); open anyway?"
Opening anyway gave an empty nano editor with something like 1/7.
Trying to leave with [ctrl-X] and [N] wasrejected and an empty nano editor with 1/2 showed up on top.
Closed the SSH window o escape this.
utterly strange
I start getting the feeling that the admin profile has or had the ability to publish as root.
There is specifically one post right now that is public where this profile commented on. That post shows up on the profile page but when this profile tries to open it or even open a notification of an answer on that post done by the admin profile a blank page get's displayed. Occasionally with a code error, occasionally with nothing at all.
This is the link of the latest notification that display a blank page:
tupambae.org/display/0ac89072-…
Uh-oh! We don't want to get too found out by the tourists!
Most Exciting Eat Streets Around Melbourne
Melbourne’s most exciting eat streets are not where you might expect
New roads, station upgrades and expanding migrant communities are changing the face of Melbourne dining.Dani Valent (The Age Good Food)
like this
Reminder: we're hiring (tenure-track equivalent) at the University of #Sydney in #ComputerScience, deadline Nov 30 (🇦🇺 time)!
usyd.wd3.myworkdayjobs.com/en-… #academicjob
Multiple Continuing (Tenure-Track) Academic Positions, School of Computer Science
Join a growing Faculty and be part of a University that places amongst the world’s best teaching and research institutions Located in the heart of Sydney’s bustling inner west quarter, close to beaches, parks, public transport and shopping districts …usyd.wd3.myworkdayjobs.com
@Muse Oh, no apologies necessary! I do the same thing, but perhaps for slightly different reasons.
Basically, if I'm not sure if someone is being earnest or making a joke, I err on the side of assuming earnestness. It just seems ... I dunno ... erring in that direction seems more respectful overall and I feel like it's less likely to become awkward for all involved.
You know every time we compare ourselves to others, it's an act of violence to self. It's a form of self-harm.
Not only that, it's disrespectful to your own unique superpowers. There is something intrinsic to your uniqueness. The thing that makes you You that no other person on this Earth can replicate.
Every time you commit this act of violence, you betray your personal experience, your starting place, the things you've overcome, your setbacks, your wins, and triumphs. Those little daily struggles only You know about.
I don't mean to be forceful, or maybe I do... but don't do that. Because every time you do, those scars cut deep, they penetrate the surface, and you run the risk of bleeding out. Trust me. I know.
– Chef Dom Taylor, Winner of Five-Star Chef, Season 1
Australia's Clive Palmer is a real piece of work.
Who Knew Queensland's richest man is a foreign investor
The Australia Institute is among NGOs and academics that for years have raised the risks of including these “Investor-State Dispute Settlement” or ISDS provisions in trade agreements.
They let foreign investors sue under a secretive international arbitration process if a government passes a law or makes a decision that harms an investor’s future profits – even if the government is acting on environmental or other public interest grounds.
The potential to undermine efforts to combat climate change is enormous.
Who knew Queensland's richest man is a foreign investor? - The Australia Institute
Clive Palmer's controversial legal strategies challenge Australia's trade agreements and environmental laws, and have profound implications for global climate action, writes Stephen Long.Chris Redman (The Australia Institute)
like this
MIDI Guitar 🎸
I worked with Noe from Adafruit on this MIDI Guitar project. I wrote the code, he did the CAD and we collaborated on the concept and components.
Adafruit Learn Guide: learn.adafruit.com/mx-midi-gui…
Adafruit's Video: youtu.be/BDwOBYsL71Q
Project Progress Playlist on Diode Zone: diode.zone/videos/watch/playli…
MX MIDI Guitar
Build a CircuitPython powered MIDI controller! 3D print the parts to build a guitar that features strumming and a whammy bar!Ruiz Brothers (Adafruit)
From Senior Lecturer to Professor level affiliated with the Faculty of Health and Life Sciences to drive world-leading research in interdisciplinary life science.
More information here: tinyurl.com/bdh7utx8
kulttuurimarxismi.eu/vermin/


















































Neal Gompa (ニール・ゴンパ)
in reply to Brodie Robertson • • •Brodie Robertson
in reply to Neal Gompa (ニール・ゴンパ) • • •Joshua Strobl
in reply to Brodie Robertson • • •@Conan_Kudo This has existed for years in Budgie as well, so not sure why Cosmic would be the thing influencing it. I implemented Notification Grouping in Budgie 10.5 in March of 2019.
buddiesofbudgie.org/blog/budgi…
Budgie 10.5 Released
buddiesofbudgie.orgBrodie Robertson
in reply to Joshua Strobl • • •Joshua Strobl
in reply to Brodie Robertson • • •razze
in reply to Brodie Robertson • • •